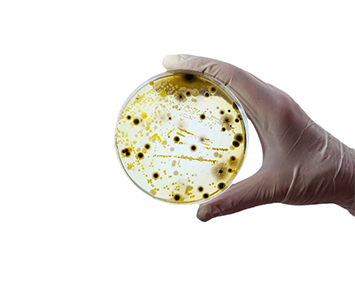
Decorative image

Postgraduate research areas
Our postgraduate A–Z lists research and professional doctorates at Keele
Find out moreStudentships
Keele studentships, funded internally or externally, can be applied for online when available
Find out moreDoctoral Training
UK Research Council funding for PGR studentships
Find out moreProfessional Doctorates
Professional doctorates offer part-time, PhD-equivalent study for working professionals
Find out moreAdmissions and application information
Explore the key areas to help you plan and submit your research degree application:
The Library Education Centre
Step-by-step guides
Covering everything from searching for resources to referencing styles and critical analysis.
Skills seminars
Enhance your research skills, academic writing, information literacy, and more.
One-to-one support
Get personalised advice from our knowledgeable staff.
Have a question about postgraduate research at Keele?
Contact us >
Visit us
This is where it begins. Whether you’re an undergraduate student visiting us for an Open Day, or a postgraduate student exploring your options at a Postgraduate Open Event, we look forward to welcoming you to our campus.
Find out moreOur Research Beacons
Revolutionising healthcare
Through advances in primary care, global health and wellbeing
Advancing sustainable futures
Innovating in life and material sciences, clean energy, and environmental resilience
Shaping the digital world
Leading research in digital society, data ethics, and technological innovation
Building Inclusivity and Communities
Through research in social inclusion, heritage, and creative cultures